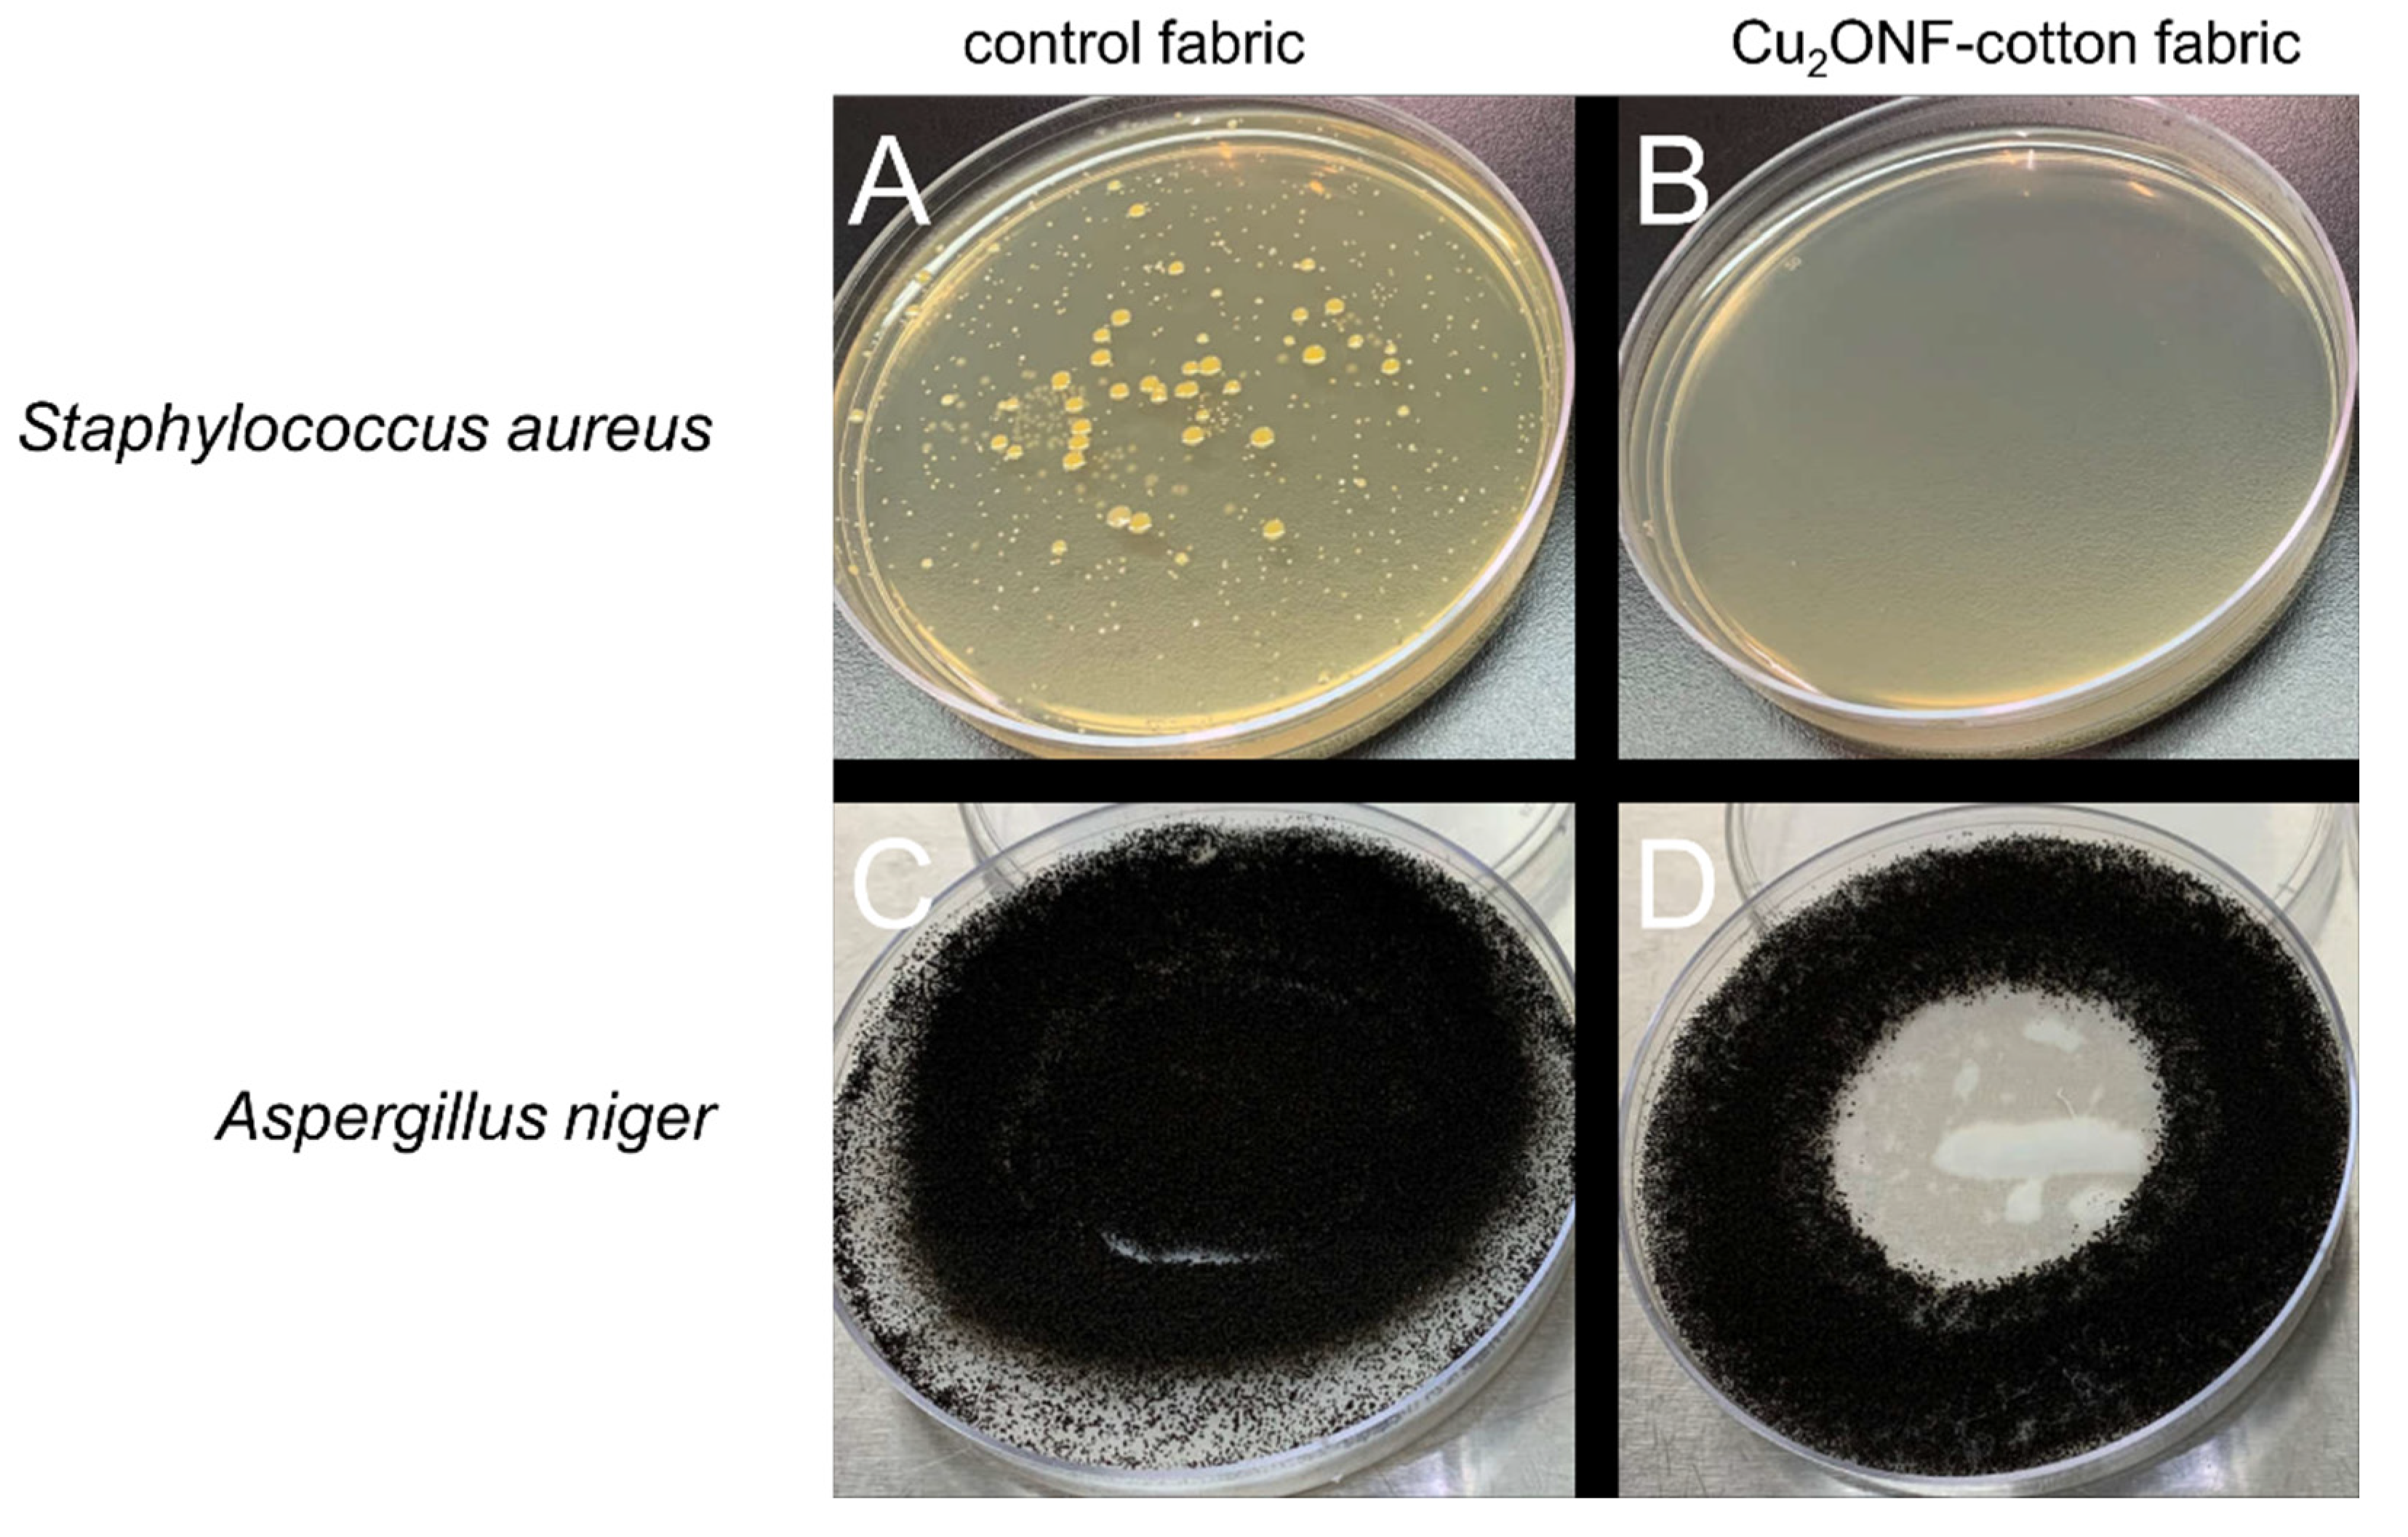
Molecules 27 07706 g009

Intrafibrillar Dispersion of Cuprous Oxide (Cu2O) Nanoflowers within Cotton Cellulose Fabrics for Permanent Antibacterial, Antifungal and Antiviral Activity
Abstract
1. Introduction
2. Materials and Methods
2.1. Materials
2.2. In Situ Synthesis of Cu2O NF-Cotton Nanocomposite Fiber
2.3. Cross-Sectional Analysis of Cu2O NF-Cotton Nanocomposite Fiber
2.4. Characterization of Cu2O NF-Cotton Nanocomposite Fiber
2.5. Time-Dependent Contact Angle Measurements
2.6. Laundering Durability Experiments of Cu2O NF-Cotton Fabric
2.7. Antibacterial, Antifungal and Antiviral Performance Experiments of Cu2O NF-Cotton Fabrics
3. Results and Discussion
3.1. Internal in Situ Formation of Cu2O NFs in Cotton Fibers
3.2. Laundering Durability Experiments of Cu2O NF-Cotton Fabric
3.3. Antibacterial, Antifungal and Antiviral Performance of Cu2O NF-Cotton Fabrics
4. Conclusions
5. Patents
Supplementary Materials
Author Contributions
Funding
Institutional Review Board Statement
Informed Consent Statement
Data Availability Statement
Acknowledgments
Conflicts of Interest
Sample Availability
References
- Shifrina, Z.B.; Matveeva, V.G.; Bronstein, L.M. Role of Polymer Structures in Catalysis by Transition Metal and Metal Oxide Nanoparticle Composites. Chem. Rev. 2020, 120, 1350–1396. [Google Scholar] [CrossRef] [PubMed]
- Rafique, M.; Shafiq, F.; Ali Gillani, S.S.; Shakil, M.; Tahir, M.B.; Sadaf, I. Eco-friendly green and biosynthesis of copper oxide nanoparticles using Citrofortunella microcarpa leaves extract for efficient photocatalytic degradation of Rhodamin B dye form textile wastewater. Optik 2020, 208, 164053. [Google Scholar] [CrossRef]
- Pan, H.; Chowdhury, S.; Premachandra, D.; Olguin, S.; Heagy, M.D. Semiconductor Photocatalysis of Bicarbonate to Solar Fuels: Formate Production from Copper(I) Oxide. ACS Sustain. Chem. Eng. 2017, 6, 1872–1880. [Google Scholar] [CrossRef]
- Sihar, N.; Tiong, T.Y.; Dee, C.F.; Ooi, P.C.; Hamzah, A.A.; Mohamed, M.A.; Majlis, B.Y. Ultraviolet Light-Assisted Copper Oxide Nanowires Hydrogen Gas Sensor. Nanoscale Res. Lett. 2018, 13, 150. [Google Scholar] [CrossRef] [PubMed]
- Hittini, W.; Abu-Hani, A.F.; Reddy, N.; Mahmoud, S.T. Cellulose-Copper Oxide hybrid nanocomposites membranes for H2S gas detection at low temperatures. Sci. Rep. 2020, 10, 2940. [Google Scholar] [CrossRef] [PubMed]
- Kim, J.; Choi, W.; Park, J.W.; Kim, C.; Kim, M.; Song, H. Branched Copper Oxide Nanoparticles Induce Highly Selective Ethylene Production by Electrochemical Carbon Dioxide Reduction. J. Am. Chem. Soc. 2019, 141, 6986–6994. [Google Scholar] [CrossRef]
- Wang, Q.; Zhang, Y.; Xiao, J.; Jiang, H.; Hu, T.; Meng, C. Copper oxide/cuprous oxide/hierarchical porous biomass-derived carbon hybrid composites for high-performance supercapacitor electrode. J. Alloys Compd. 2019, 782, 1103–1113. [Google Scholar] [CrossRef]
- Qiu, D.; Zhao, B.; Lin, Z.; Pu, L.; Pan, L.; Shi, Y. In situ growth of CuO nanoparticles on graphene matrix as anode material for lithium-ion batteries. Mater. Lett. 2013, 105, 242–245. [Google Scholar] [CrossRef]
- Kooter, I.; Ilves, M.; Grollers-Mulderij, M.; Duistermaat, E.; Tromp, P.C.; Kuper, F.; Kinaret, P.; Savolainen, K.; Greco, D.; Karisola, P.; et al. Molecular Signature of Asthma-Enhanced Sensitivity to CuO Nanoparticle Aerosols from 3D Cell Model. ACS Nano 2019, 13, 6932–6946. [Google Scholar] [CrossRef]
- Kalaiarasi, A.; Sankar, R.; Anusha, C.; Saravanan, K.; Aarthy, K.; Karthic, S.; Mathuram, T.L.; Ravikumar, V. Copper oxide nanoparticles induce anticancer activity in A549 lung cancer cells by inhibition of histone deacetylase. Biotechnol. Lett. 2018, 40, 249–256. [Google Scholar] [CrossRef]
- Simonin, M.; Cantarel, A.A.M.; Crouzet, A.; Gervaix, J.; Martins, J.M.F.; Richaume, A. Negative Effects of Copper Oxide Nanoparticles on Carbon and Nitrogen Cycle Microbial Activities in Contrasting Agricultural Soils and in Presence of Plants. Front. Microbiol. 2018, 9, 3102. [Google Scholar] [CrossRef] [PubMed]
- Sathiyavimal, S.; Vasantharaj, S.; Bharathi, D.; Saravanan, M.; Manikandan, E.; Kumar, S.S.; Pugazhendhi, A. Biogenesis of copper oxide nanoparticles (CuONPs) using Sida acuta and their incorporation over cotton fabrics to prevent the pathogenicity of Gram negative and Gram positive bacteria. J. Photochem. Photobiol. B 2018, 188, 126–134. [Google Scholar] [CrossRef]
- Gouda, M.; Aljaafari, A.; Al-Fayz, Y.; Boraie, W.E. Preparation and Characterization of Some Nanometal Oxides Using Microwave Technique and Their Application to Cotton Fabrics. J. Nanomater. 2015, 2015, 586904. [Google Scholar] [CrossRef]
- Pargai, D.; Jahan, S. Application of Vitis vinifera Microcapsules on Cotton Fabric: A Potential to Prevent UV-Induced Skin Problems. J. Nat. Fibers 2018, 17, 412–426. [Google Scholar] [CrossRef]
- Radetić, M.; Marković, D. Nano-finishing of cellulose textile materials with copper and copper oxide nanoparticles. Cellulose 2019, 26, 8971–8991. [Google Scholar] [CrossRef]
- Gniadek, M.; Dabrowska, A. The marine nano- and microplastics characterisation by SEM-EDX: The potential of the method in comparison with various physical and chemical approaches. Mar. Pollut. Bull. 2019, 148, 210–216. [Google Scholar] [CrossRef] [PubMed]
- Prata, J.C.; da Costa, J.P.; Lopes, I.; Duarte, A.C.; Rocha-Santos, T. Environmental exposure to microplastics: An overview on possible human health effects. Sci. Total Environ. 2020, 702, 134455. [Google Scholar] [CrossRef] [PubMed]
- Xia, B.; Zhang, J.; Zhao, X.; Feng, J.; Teng, Y.; Chen, B.; Sun, X.; Zhu, L.; Sun, X.; Qu, K. Polystyrene microplastics increase uptake, elimination and cytotoxicity of decabromodiphenyl ether (BDE-209) in the marine scallop Chlamys farreri. Environ. Pollut. 2020, 258, 113657. [Google Scholar] [CrossRef]
- Yu, H.; Zhang, X.; Hu, J.; Peng, J.; Qu, J. Ecotoxicity of polystyrene microplastics to submerged carnivorous Utricularia vulgaris plants in freshwater ecosystems. Environ. Pollut. 2020, 265, 114830. [Google Scholar] [CrossRef]
- Wang, S.; Wang, Y.; Liang, Y.; Cao, W.; Sun, C.; Ju, P.; Zheng, L. The interactions between microplastic polyvinyl chloride and marine diatoms: Physiological, morphological, and growth effects. Ecotoxicol. Environ. Saf. 2020, 203, 111000. [Google Scholar] [CrossRef]
- Wang, Y.; Xiao, D.; Zhong, Y.; Liu, Y.; Zhang, L.; Chen, Z.; Sui, X.; Wang, B.; Feng, X.; Xu, H.; et al. Preparation and characterization of carboxymethylated cotton fabrics as hemostatic wound dressing. Int. J. Biol. Macromol. 2020, 160, 18–25. [Google Scholar] [CrossRef] [PubMed]
- Broadhead, R.; Craeye, L.; Callewaert, C. The Future of Functional Clothing for an Improved Skin and Textile Microbiome Relationship. Microorganisms 2021, 9, 1192. [Google Scholar] [CrossRef] [PubMed]
- Szostak-Kotowa, J. Biodeterioration of textiles. Int. Biodeterior. Biodegrad. 2004, 53, 165–170. [Google Scholar] [CrossRef]
- Meghana, S.; Kabra, P.; Chakraborty, S.; Padmavathy, N. Understanding the pathway of antibacterial activity of copper oxide nanoparticles. RSC Adv. 2015, 5, 12293–12299. [Google Scholar] [CrossRef]
- Firmansyah, D.A.; Kim, T.; Kim, S.; Sullivan, K.; Zachariah, M.R.; Lee, D. Crystalline Phase Reduction of Cuprous Oxide (Cu2O) Nanoparticles Accompanied by a Morphology Change during Ethanol-Assisted Spray Pyrolysis. Langmuir ACS J. Surf. Colloids 2009, 25, 7063–7071. [Google Scholar] [CrossRef]
- Bhosale, M.A.; Bhatte, K.D.; Bhanage, B.M. A rapid, one pot microwave assisted synthesis of nanosize cuprous oxide. Powder Technol. 2013, 235, 516–519. [Google Scholar] [CrossRef]
- Yadav, S.; Jain, A.; Malhotra, P. A review on the sustainable routes for the synthesis and applications of cuprous oxide nanoparticles and their nanocomposites. Green Chem. 2019, 21, 937–955. [Google Scholar] [CrossRef]
- Brumbaugh, A.D.; Cohen, K.A.; St Angelo, S.K. Ultrasmall Copper Nanoparticles Synthesized with a Plant Tea Reducing Agent. Acs Sustain. Chem. Eng. 2014, 2, 1933–1939. [Google Scholar] [CrossRef]
- Marković, D.; Deeks, C.; Nunney, T.; Radovanović, Ž.; Radoičić, M.; Šaponjić, Z.; Radetić, M. Antibacterial activity of Cu-based nanoparticles synthesized on the cotton fabrics modified with polycarboxylic acids. Carbohydr. Polym. 2018, 200, 173–182. [Google Scholar] [CrossRef]
- Perelshtein, I.; Ruderman, Y.; Perkas, N.; Beddow, J.; Singh, G.; Vinatoru, M.; Joyce, E.; Mason, T.J.; Blanes, M.; Molla, K.; et al. The sonochemical coating of cotton withstands 65 washing cycles at hospital washing standards and retains its antibacterial properties. Cellulose 2013, 20, 1215–1221. [Google Scholar] [CrossRef]
- Kanade, P.; Patel, B. Copper nano-sol loaded woven fabrics: Structure and color characterization. Fash. Text. 2017, 4, 43. [Google Scholar] [CrossRef]
- Alho, L.O.G.; Souza, J.P.; Rocha, G.S.; Mansano, A.D.S.; Lombardi, A.T.; Sarmento, H.; Melao, M.G.G. Photosynthetic, morphological and biochemical biomarkers as tools to investigate copper oxide nanoparticle toxicity to a freshwater chlorophyceae. Environ. Pollut. 2020, 265, 114856. [Google Scholar] [CrossRef] [PubMed]
- Mansano, A.S.; Souza, J.P.; Cancino-Bernardi, J.; Venturini, F.P.; Marangoni, V.S.; Zucolotto, V. Toxicity of copper oxide nanoparticles to Neotropical species Ceriodaphnia silvestrii and Hyphessobrycon eques. Environ. Pollut. 2018, 243, 723–733. [Google Scholar] [CrossRef] [PubMed]
- Wu, F.; Harper, B.J.; Crandon, L.E.; Harper, S.L. Assessment of Cu and CuO nanoparticle ecological responses using laboratory small-scale microcosms. Environ. Sci. Nano 2020, 7, 105–115. [Google Scholar] [CrossRef] [PubMed]
- Boylston, E.K.; Hinojosa, O.; Hebert, J.J. A quick embedding method for light and electron microscopy of textile fibers. Biotech. Histochem. 1991, 66, 122–124. [Google Scholar] [CrossRef] [PubMed]
- Thibodeaux, D.P.; Evans, J.P. Cotton Fiber Maturity by Image Analysis. Text. Res. J. 2016, 56, 130–139. [Google Scholar] [CrossRef]
- Schneider, C.A.; Rasband, W.S.; Eliceiri, K.W. NIH Image to ImageJ: 25 years of image analysis. Nat. Methods 2012, 9, 671–675. [Google Scholar] [CrossRef]
- Cuppett, J.D.; Duncan, S.E.; Dietrich, A.M. Evaluation of copper speciation and water quality factors that affect aqueous copper tasting response. Chem. Senses 2006, 31, 689–697. [Google Scholar] [CrossRef]
- Österbeg, M.; Claesson, P.M. Interactions between cellulose surfaces: Effect of solution pH. J. Adhes. Sci. Technol. 2000, 14, 603–618. [Google Scholar] [CrossRef]
- Heymann, E.; Rabinov, G. The Acid Nature of Cellulose. I. Equilibria between Cellulose and Salts. J. Phys. Chem. 2002, 45, 1152–1166. [Google Scholar] [CrossRef]
- Kongdee, A.; Bechtold, T. The complexation of Fe(III)-ions in cellulose fibres: A fundamental property. Carbohydr. Polym. 2004, 56, 47–53. [Google Scholar] [CrossRef]
- Burger, J.; Kettenbach, G.; Klüfers, P. Coordination equilibria in transition metal based cellulose solvents. Macromol. Symp. 1995, 99, 113–126. [Google Scholar] [CrossRef]
- Li, Y.; Li, Y.; Huang, L.; Bin, Q.; Lin, Z.; Yang, H.; Cai, Z.; Chen, G. Molecularly imprinted fluorescent and colorimetric sensor based on TiO2@Cu(OH)2 nanoparticle autocatalysis for protein recognition. J. Mater. Chem. B 2013, 1, 1256–1262. [Google Scholar] [CrossRef] [PubMed]
- Topnani, N.; Kushwaha, S.; Athar, T. Wet Synthesis of Copper Oxide Nanopowder. Int. J. Green Nanotechnol. Mater. Sci. Eng. 2010, 1, M67–M73. [Google Scholar] [CrossRef]
- Renuga, D.; Jeyasundari, J.; Athithan, A.S.S.; Jacob, Y.B.A. Synthesis and characterization of copper oxide nanoparticles using Brassica oleracea var. italic extract for its antifungal application. Mater. Res. Express 2020, 7, 045007. [Google Scholar] [CrossRef]
- Ling, Z.; Wang, T.; Makarem, M.; Santiago Cintrón, M.; Cheng, H.N.; Kang, X.; Bacher, M.; Potthast, A.; Rosenau, T.; King, H.; et al. Effects of ball milling on the structure of cotton cellulose. Cellulose 2019, 26, 305–328. [Google Scholar] [CrossRef]
- Zhou, T.; Xu, H.; Cai, L.; Wang, J. Construction of anti-flame network structures in cotton fabrics with pentaerythritol phosphate urea salt and nano SiO2. Appl. Surf. Sci. 2020, 507, 145175. [Google Scholar] [CrossRef]
- Vinod Kumar, V.; Dharani, A.; Mariappan, M.; Anthony, S.P. Synthesis of CuO and Cu2O nano/microparticles from a single precursor: Effect of temperature on CuO/Cu2O formation and morphology dependent nitroarene reduction. RSC Adv. 2016, 6, 85083–85090. [Google Scholar] [CrossRef]
- Jordan, J.H.; Easson, M.W.; Dien, B.; Thompson, S.; Condon, B.D. Extraction and characterization of nanocellulose crystals from cotton gin motes and cotton gin waste. Cellulose 2019, 26, 5959–5979. [Google Scholar] [CrossRef]
- Biesinger, M.C. Advanced analysis of copper X-ray photoelectron spectra. Surf. Interface Anal. 2017, 49, 1325–1334. [Google Scholar] [CrossRef]
- Biesinger, M.C.; Lau, L.W.M.; Gerson, A.R.; Smart, R.S.C. Resolving surface chemical states in XPS analysis of first row transition metals, oxides and hydroxides: Sc, Ti, V, Cu and Zn. Appl. Surf. Sci. 2010, 257, 887–898. [Google Scholar] [CrossRef]
- Hage, J.L.T.; Reuter, M.A.; Schuiling, R.D.; Ramtahalsing, I.S. Reduction of copper with cellulose in an autoclave; an alternative to electrolysis? Miner. Eng. 1999, 12, 393–404. [Google Scholar] [CrossRef]
- Nam, S.; Hillyer, M.B.; Condon, B.D.; Lum, J.S.; Richards, M.N.; Zhang, Q. Silver Nanoparticle-Infused Cotton Fiber: Durability and Aqueous Release of Silver in Laundry Water. J. Agric. Food Chem. 2020, 68, 13231–13240. [Google Scholar] [CrossRef] [PubMed]
- Logpriya, S.; Bhuvaneshwari, V.; Vaidehi, D.; SenthilKumar, R.P.; Nithya Malar, R.S.; Pavithra Sheetal, B.; Amsaveni, R.; Kalaiselvi, M. Preparation and characterization of ascorbic acid-mediated chitosan–copper oxide nanocomposite for anti-microbial, sporicidal and biofilm-inhibitory activity. J. Nanostruct. Chem. 2018, 8, 301–309. [Google Scholar] [CrossRef]
- Sharma, P.; Pant, S.; Dave, V.; Tak, K.; Sadhu, V.; Reddy, K.R. Green synthesis and characterization of copper nanoparticles by Tinospora cardifolia to produce nature-friendly copper nano-coated fabric and their antimicrobial evaluation. J. Microbiol. Methods 2019, 160, 107–116. [Google Scholar] [CrossRef]
- Oprea, M.; Panaitescu, D.M. Nanocellulose Hybrids with Metal Oxides Nanoparticles for Biomedical Applications. Molecules 2020, 25, 4045. [Google Scholar] [CrossRef]

| Pathogen | Classification | Percent Inhibition (%) |
|---|---|---|
| Klebsiella pneumoniae | Gram-negative bacterium | >99.99994 |
| Escherichia coli | Gram-negative bacterium | 99.9998 |
| Staphylococcus aureus | Gram-positive bacterium | 99.995 |
| Aspergillus niger | Fungus | Complete inhibition |
| Human coronavirus, 229E strain | Enveloped RNA virus | ≥90 |
Publisher’s Note: MDPI stays neutral with regard to jurisdictional claims in published maps and institutional affiliations. |
© 2022 by the authors. Licensee MDPI, Basel, Switzerland. This article is an open access article distributed under the terms and conditions of the Creative Commons Attribution (CC BY) license (https://creativecommons.org/licenses/by/4.0/).
Share and Cite
Hillyer, M.B.; Nam, S.; Condon, B.D. Intrafibrillar Dispersion of Cuprous Oxide (Cu2O) Nanoflowers within Cotton Cellulose Fabrics for Permanent Antibacterial, Antifungal and Antiviral Activity. Molecules 2022, 27, 7706. https://doi.org/10.3390/molecules27227706
Hillyer MB, Nam S, Condon BD. Intrafibrillar Dispersion of Cuprous Oxide (Cu2O) Nanoflowers within Cotton Cellulose Fabrics for Permanent Antibacterial, Antifungal and Antiviral Activity. Molecules. 2022; 27(22):7706. https://doi.org/10.3390/molecules27227706
Chicago/Turabian StyleHillyer, Matthew B., Sunghyun Nam, and Brian D. Condon. 2022. "Intrafibrillar Dispersion of Cuprous Oxide (Cu2O) Nanoflowers within Cotton Cellulose Fabrics for Permanent Antibacterial, Antifungal and Antiviral Activity" Molecules 27, no. 22: 7706. https://doi.org/10.3390/molecules27227706
APA StyleHillyer, M. B., Nam, S., & Condon, B. D. (2022). Intrafibrillar Dispersion of Cuprous Oxide (Cu2O) Nanoflowers within Cotton Cellulose Fabrics for Permanent Antibacterial, Antifungal and Antiviral Activity. Molecules, 27(22), 7706. https://doi.org/10.3390/molecules27227706

